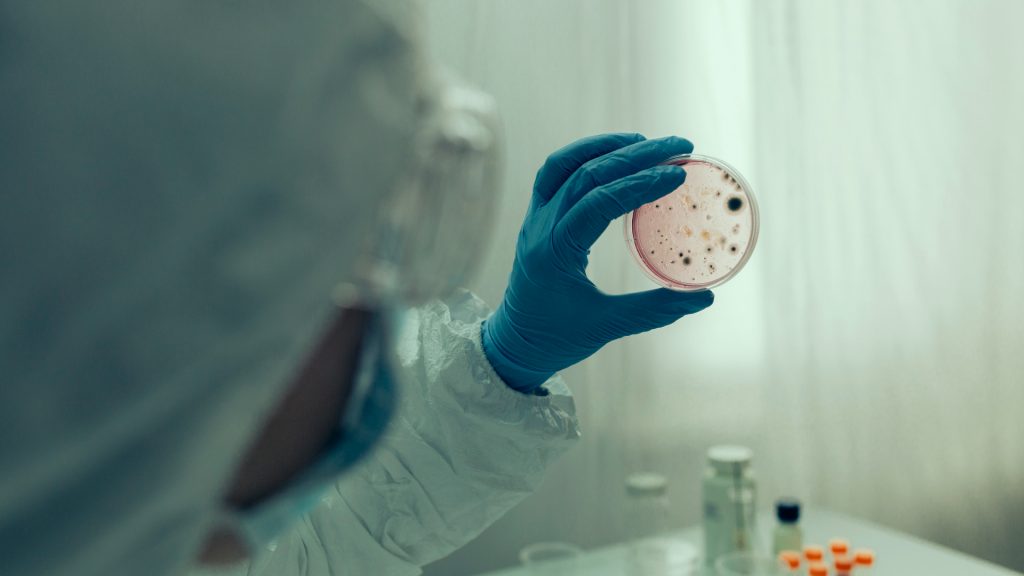

Si te hablamos de los bacteriófagos, también llamados fagos probablemente no sepas a qué nos referimos. Y es que estos virus no son todavía muy conocidos aunque su descubrimiento se remonta a hace más de cien años, cuando el microbiólogo canadiense Félix d’Herelle dio con ellos. Se trata de virus que infectan a las bacterias y son capaces de matar a las responsables de diversas enfermedades. Por eso son una alternativa ante los problemas de resistencia a los antibióticos, explican desde la web de la OCU.
Y es que este tipo de bacterias, resistentes a los antibióticos son, según la OMS, una de las diez mayores amenazas para la salud pública a las que se enfrenta la humanidad, y según estima la Organización, para 2050 causarán unos diez millones de muertes.
Desde 20Minutos aluden a un estudio de la Sociedad Española de Enfermedades Infecciosas y Microbiología Clínica (Seimc) realizado en 130 hospitales, que alerta de que más de 20.000 personas fallecen al año tras ser diagnosticadas de infección por bacterias multirresistentes. En este escenario, los fagos son una opción con resultados muy prometedores, aunque todavía minoritaria, básicamente por falta de financiación, explican.
La forma de actuar de los fagos es la siguiente: se unen a la bacteria patógena huésped, introducen su material genético, se replican en su interior y la destruyen. De esta manera, a partir de un fago se producen nuevas generaciones de virus listas para actuar sobre el resto de bacterias del mismo tipo, originando una reacción en cadena que elimina al patógeno», explican desde la OCU.
La investigadora del Instituto de Biología Integrativa de Sistemas (I2SysBio), centro de la Universitat de València y del CSIC, Pilar Domingo-Calap, investiga precisamente los fagos y afirma que su uso todavía es muy específico y de forma compasiva ya que no hay regulación al respecto, ni por parte de la Agencia Europea del Medicamento (EMA, por sus siglas en inglés) ni por parte de la Agencia Española de Medicamentos y Productos Sanitarios (Aemps). Esto, a su vez, hace que no se pueda solicitar desde un hospital un tratamiento con fagos como algo rutinario y habla de la necesidad de ensayos clínicos e inversión para que cualquier persona pueda tener acceso a la fagoterapia.
Con el aumento de la resistencia bacteriana, el interés en los fagos ha resurgido. «Los usamos de forma distinta, como medicina personalizada: desarrollamos fagos optimizados con evolución dirigida para las bacterias específicas de cada paciente», explica. Y con respecto a donde conseguirlos, la bióloga es de lo más descriptiva, es como «ir al campo y cazar virus», explica y añade que: «Están en cualquier sitio, en cualquier lugar podemos encontrar un fago adecuado para una bacteria concreta», “Los virus están en el suelo, el aire y el agua. Hay que buscarlos continuamente, en cualquier sitio”, matiza.
Domingo-Calap, habla de los fagos como una opción muy prometedora a implementar, demostrada su eficacia, ya que «nadie está a salvo de una infección por una de estas ‘superbacterias’…Cualquier persona puede morir tras coger una bacteria multirressistente, no hace falta ser vulnerable o inmunodeprimido», explica y añade que puede llegar a un punto en el que morirá más gente por esta razón que por cáncer.
Desde la OCU hablan de las ventajas de su uso entre las que están, que son muy específicos y atacan solo a la bacteria diana, no tienen efectos secundarios ni afectan a la microflora intestinal y la probabilidad de aparición de resistencias a antibióticos es muy baja, además de que la muerte de las bacterias conlleva la multiplicación de los fagos.
MÁS SOBRE:
© Sociedad Española de Radio Difusión, S.L.U.
© Sociedad Española de Radiodifusión realiza una reserva expresa de las reproducciones y usos de las obras y otras prestaciones accesibles desde este sitio web a medios de lectura mecánica u otros medios que resulten adecuados a tal fin de conformidad con el artículo 67.3 del Real Decreto-ley 24/2021, de 2 de noviembre.